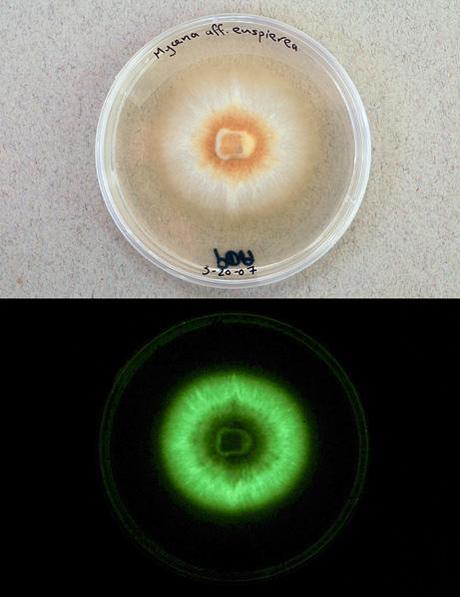
Glowing Mushrooms - Champignons Phosphorescents

Le biologiste Dennis Desjardin de l'Université de San Francisco State et son équipe ont découvert sept nouvelles espèces de champignons luisants au Belize, au Brésil, en République Dominicaine, en Jamaïque, au Japon, en Malaysie et à Puerto Rico.
Seven new glow-in-the-dark mushroom species have been discovered by San Francisco State University Biology Professor Dennis Desjardin and colleagues.
They discovered the psychedelic fungi in Belize, Brazil, Dominican Republic, Jamaica, Japan, Malaysia and Puerto Rico. The discoveries include four species new to science and three new reports of luminescence in known species.

Liens, links:
Glowing Mushroom Pictures @ National Geographic
Via: BoingBoing